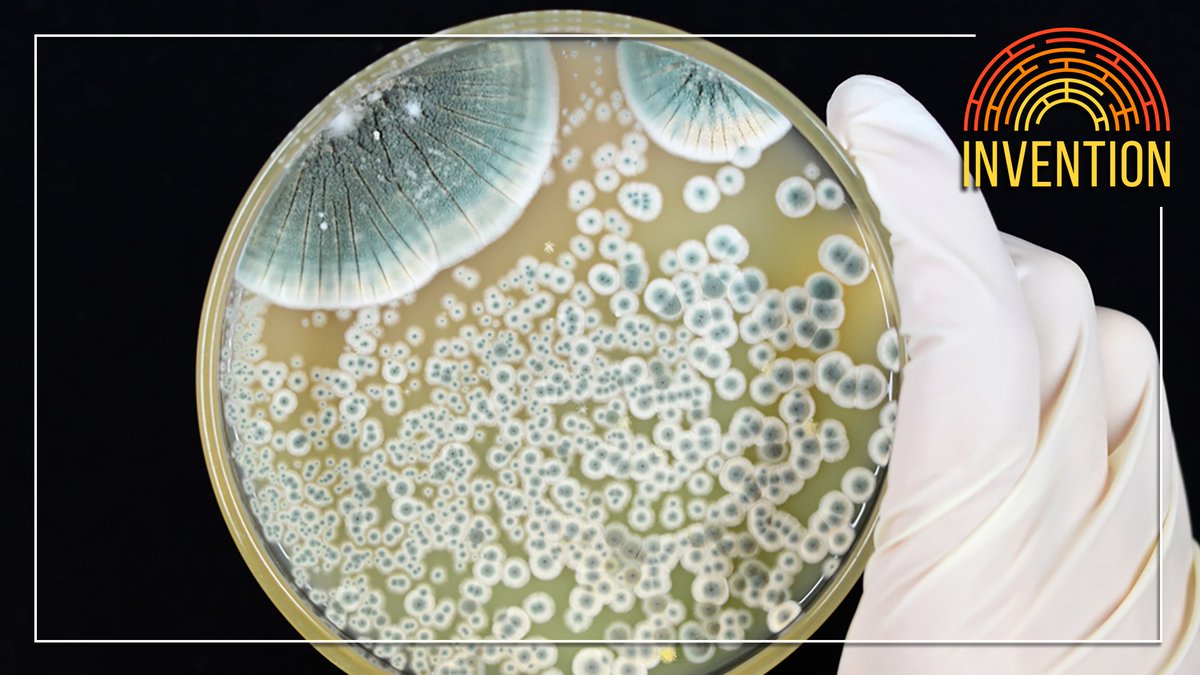
Invention Classic: Penicillin megaphone.link/invention

A fungal accident in the early 20th century opened the door for the medical wonders of the antibiotic age. In this episode, learn what came before and how Alexander Fleming’s discovery changed the world. (Published 7/15/19)

Invention Podcast
@stbyminvention
Explore the inventions we created and how they created us! A #science #history #podcast from @iHeartPodcasts & @BLOWtheMIND hosts Robert Lamb and Joe McCormick.
ID: 1057273439768207363
https://megaphone.link/invention 30-10-2018 14:10:06
103 Tweet
479 Followers
81 Following